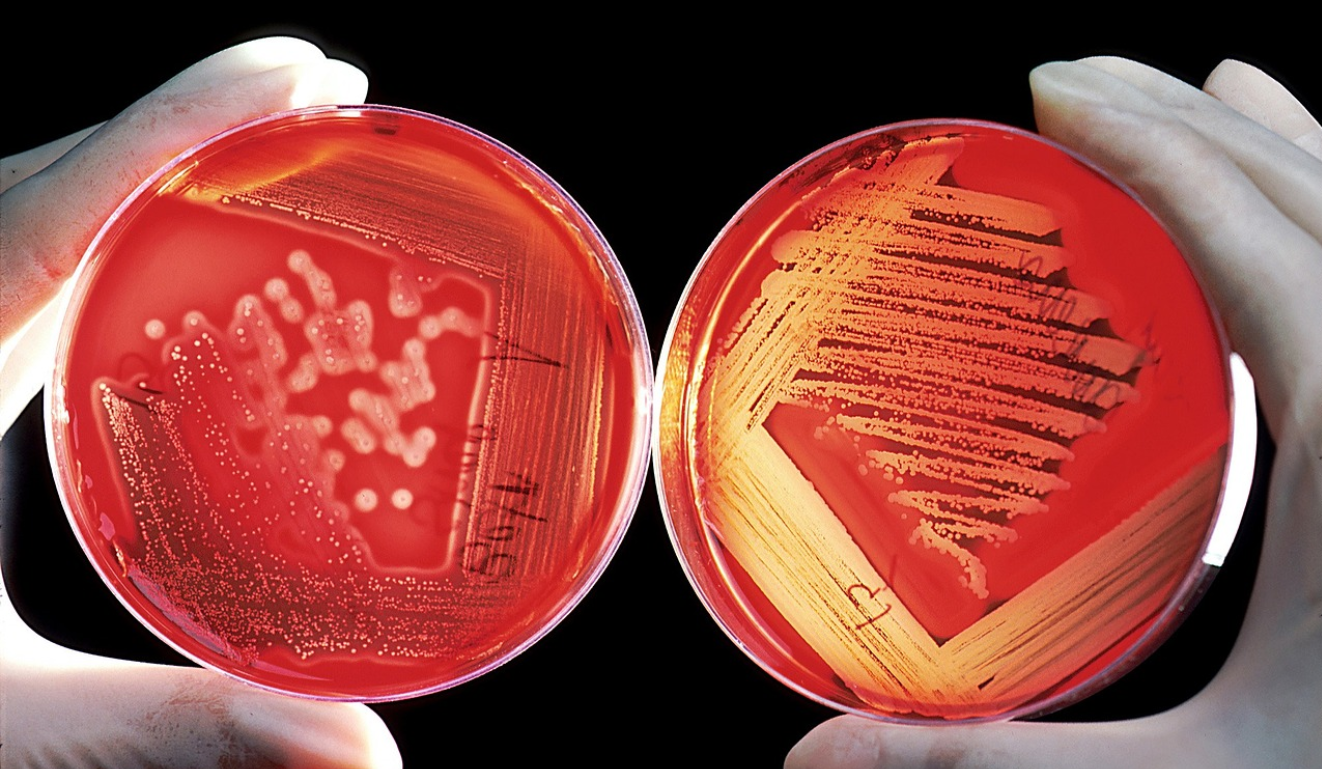
셀트리온주가-배당금

셀트리온은 셀트리온헬스케어, 셀트리온제약의 합병이슈가 불거지며 주주들이 관심을 갖고 바라보고 있습니다. 이 글을 통해 셀트리온합병 이슈와 주가 배당 등 다양한 정보를 알아보도록 하겠습니다.
[스타즈IR] 셀트리온 '3사 합병' 첫 발…2030년 매출 12조 순항
셀트리온(068270)이 셀트리온헬스케어(091990)에 이어 내년 6월 셀트리온제약(068760)까지 3사 합병을 완료해 ‘글로벌 빅파마(대형 제약·바이오 업체)’로 도약한다. 3사가 합병한 셀트리온이 미국
n.news.naver.com
목차
1. 셀트리온 주가
2. 셀트리온 주가전망
3. 셀트리온 배당
4. 셀트리온 기업분석

1. 셀트리온 주가
바이오의약품 관련주 셀트리온은 2017년 바이오시밀러 붐이 일어나며 개인들이 가장 좋아하는 주식 가운데 한 기업으로 자리 잡았습니다. 코스닥에 상장을 시작하여 코스닥 기준 시총 1위에 오르기도 한 셀트리온은 코스피로 이전하여 보다 안정적인 기업으로 성장하고 있습니다. 최근 셀트리온헬스케어, 셀트리온제약과의 합병 이슈로 주가의 변동성이 커지고 있습니다.

2020년 12월 ~ 현재(하락기)
- 2020년 12월 37만 원대의 고점 이후 약 3년간 우하향 하며 14만 원대까지 주가가 하락
- 코로나 치료제 백신의 기대감 소멸 - 셀트리온헬스케어, 셀트리온제약의 합병 지연
2020년 3월 ~ 2020년 12월
- 코로나로 인해 30만 원대였던 주가가 12만 원대까지 하락
- 코로나 치료제, 백신 개발발표에 따른 기대감으로 인한 주가상승 - 호실적에 따른 주가 상승
2018년 3월 ~ 2020년 3월(하락기)
- 미중 관계 악화에 따른 주식시장 악화로 주가 하락
- 코로나로 인한 단기 충격으로 하락
2017년 3월 ~ 2018년 3월(상승기)
- 74,661원이었던 주가는 341,521원까지 상승
- 바이오시밀러 의약품의 기대감으로 인한 수급 집중
2. 셀트리온 주가전망
셀트리온의 사업 영역인 바이오시밀러 시장은 매년 큰 폭의 성장을 이어가고 있습니다. 당사는 바이오시밀러리 분야에 있어 세계적으로도 경쟁력을 갖추고 있습니다. 이를 바탕으로 미국, 유럽, 캐나다 등 해외진출을 지속적으로 넓혀 가고 있으며 지속적으로 경쟁력을 키워나가고 있어 회사의 기술력 실적면으로 보았을 때는 전망이 밝다고 볼 수 있습니다.
3. 셀트리온 배당
셀트리온은 매년 잉여현금흐름에 영향을 주지 않는 선에서 2~5% 정도의 배당을 시행하고 있습니다. 셀트리온의 최근 배당 내역과 2023년 배당에 대한 정보는 아래와 같습니다.
2021년 ▶ 750원
2022년 ▶ 375원
4. 셀트리온 기업분석
셀트리온은 1991년 설립되어 2005년 코스닥에서 주식거래가 시작되었습니다. 이후 2018년 보다 안정적인 거래를 위해 코스피로 이전상장을 하였습니다. 셀트리온은 생명공학기술과 세포배양 기술을 기반으로 항체의약품과 바이오시밀러의약품을 생산하고 판매하는 사업을 영위하고 있습니다. 당사의 대표적인 제품으로는 램시마가 있으며 램시마는 세계 최초로 유럽과 미국에서 허가를 받은 제품으로 알려졌습니다. 당사는 현재 100개가 넘는 국가에 바이오시밀러제품을 납품하고 있으며 지속적인 연구분야 투자로 해당분야 선도기업으로 성장하기 위해 노력하고 있습니다.
美 염증성 장질환 대가 “셀트리온 '짐펜트라', 환자의 삶 개선시킬 것”
염증성 장질환(IBD) 대가이자 얀센의 레미케이드(인플릭시맙) 임상 주저자인 미국 노스웨스턴대의 스테판 하나우어 교수(사진)가 레미케이드의 피하주사(SC) 제형 의약품 짐펜트라에 대해 “지속
n.news.naver.com

'기업 > 제약바이오' 카테고리의 다른 글
| 인터로조 주가 전망 배당금 알아보기 (0) | 2023.12.19 |
|---|---|
| 셀트리온헬스케어 주가 전망 배당금 알아보기 (0) | 2023.12.15 |
| HLB 주가 전망 기업분석 알아보기 (0) | 2023.11.23 |
| 현대바이오 주가 전망 코로나치료제 관련주 (0) | 2023.11.21 |
| 알테오젠 주가 전망 머크매각 알아보기 (0) | 2023.11.15 |

